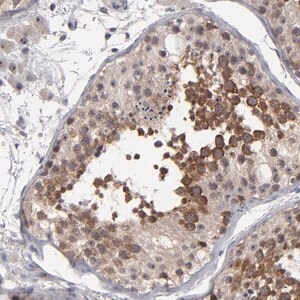

Merck Anti-GLCCI1 antibody produced in rabbit
상품 한눈에 보기
토끼에서 생산된 Anti-GLCCI1 항체로, Glucocorticoid-induced transcript 1 단백질을 인식합니다. Affinity purified Prestige Antibody® 제품으로 Atlas Antibodies 기술 기반. 연구용 단백질 검출 및 분석에 적합한 buffered aqueous glycerol 용액 형태.
브랜드: Merck Sigma
✨AI 추천 연관 상품
AI가 분석한 이 상품과 연관된 추천 상품들을 확인해보세요
연관 상품을 찾고 있습니다...
Anti-GLCCI1 antibody produced in rabbit
제품 개요
Ab1, Prestige Antibodies® Powered by Atlas Antibodies
Affinity isolated antibody, buffered aqueous glycerol solution.
상세 설명
Anti-Glucocorticoid-induced transcript 1 protein antibody produced in rabbit.
Glucocorticoid-induced transcript 1 protein recombinant protein epitope signature tag (PrEST).
제품 사양
| 항목 | 내용 |
|---|---|
| 제품명 | Anti-GLCCI1 antibody produced in rabbit |
| 호스트 | Rabbit |
| 타깃 단백질 | Glucocorticoid-induced transcript 1 protein |
| 정제 방식 | Affinity isolated |
| 형태 | Buffered aqueous glycerol solution |
| 브랜드 | Prestige Antibodies® Powered by Atlas Antibodies |
| 공급업체 | Merck Sigma |
🏷️Merck Sigma 상품 둘러보기
동일 브랜드의 다른 상품들을 확인해보세요

Merck Sigma
Merck Anti-GGT5 antibody produced in rabbit
370,530원

Merck Sigma
Merck Anti-GIT1 antibody produced in rabbit
817,800원

Merck Sigma
Merck Anti-GLCCI1 antibody produced in rabbit
895,700원

Merck Sigma
Merck Anti-UPK3B antibody produced in rabbit
370,530원

Merck Sigma
Merck Anti-USP13 antibody produced in rabbit
370,530원
배송/결제/교환/반품 안내
배송 정보
| 기본 배송비 |
| 교환/반품 배송비 |
|
|---|---|---|---|
| 착불 배송비 |
| ||
| 교환/반품 배송비 |
| ||
결제 및 환불 안내
| 결제수단 |
|
|---|---|
| 취소 |
|
| 반품 |
|
| 환급 |
|
교환 및 반품 접수
| 교환 및 반품 접수 기한 |
|
|---|---|
| 교환 및 반품 접수가 가능한 경우 |
|
| 교환 및 반품 접수가 불가능한 경우 |
|
교환 및 반품 신청
| 교환 절차 |
|
|---|---|
| 반품 절차 |
|
문의 0
로그인 후 문의를 할 수 있습니다.